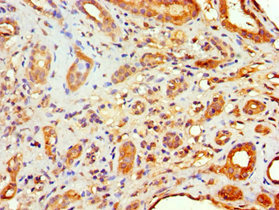

FLOT2 Antibody
-
中文名稱:FLOT2兔多克隆抗體
-
貨號:CSB-PA619868ESR1HU
-
規格:¥440
-
圖片:
-
Western blot
All lanes: Flotillin-2 antibody at 4μg/ml
Lane 1: A549 whole cell lysate
Lane 2: Hela whole cell lysate
Lane 3: Rat brain tissue
Secondary
Goat polyclonal to rabbit IgG at 1/10000 dilution
Predicted band size: 47 kDa
Observed band size: 47 kDa -
Immunohistochemistry of paraffin-embedded human tonsil tissue using CSB-PA619868ESR1HU at dilution of 1:100
-
Immunohistochemistry of paraffin-embedded human kidney tissue using CSB-PA619868ESR1HU at dilution of 1:100
-
-
其他:
產品詳情
-
產品名稱:Rabbit anti-Homo sapiens (Human) FLOT2 Polyclonal antibody
-
Uniprot No.:
-
基因名:
-
別名:ECS-1 antibody; ECS1 antibody; Epidermal surface antigen 1 antibody; Epidermal surface antigen antibody; ESA antibody; ESA1 antibody; Flot2 antibody; FLOT2_HUMAN antibody; Flotillin 2 (epidermal surface antigen 1) antibody; Flotillin-2 antibody; M17S1 antibody; Membrane component chromosome 17 surface marker 1 antibody; Membrane component chromosome 17 surface marker 1 homolog antibody; membrane component; chromosome 17; surface marker 1 (35kD protein identified by monoclonal antibody ECS-1) antibody; Membrane component; chromosome 17; surface marker 1 antibody; REG-1 antibody; Reggie-1 antibody; Reggie-2 antibody
-
宿主:Rabbit
-
反應種屬:Human, Rat
-
免疫原:Recombinant Human Flotillin-2 protein (239-428AA)
-
免疫原種屬:Homo sapiens (Human)
-
標記方式:Non-conjugated
-
克隆類型:Polyclonal
-
抗體亞型:IgG
-
純化方式:Antigen Affinity Purified
-
濃度:It differs from different batches. Please contact us to confirm it.
-
保存緩沖液:PBS with 0.02% sodium azide, 50% glycerol, pH7.3.
-
產品提供形式:Liquid
-
應用范圍:ELISA, WB, IHC
-
推薦稀釋比:
Application Recommended Dilution WB 1:500-1:2000 IHC 1:20-1:200 -
Protocols:
-
儲存條件:Upon receipt, store at -20°C or -80°C. Avoid repeated freeze.
-
貨期:Basically, we can dispatch the products out in 1-3 working days after receiving your orders. Delivery time maybe differs from different purchasing way or location, please kindly consult your local distributors for specific delivery time.
-
用途:For Research Use Only. Not for use in diagnostic or therapeutic procedures.
相關產品
靶點詳情
-
功能:May act as a scaffolding protein within caveolar membranes, functionally participating in formation of caveolae or caveolae-like vesicles. May be involved in epidermal cell adhesion and epidermal structure and function.
-
基因功能參考文獻:
- miR-133 involves in lung adenocarcinoma cell metastasis by targeting FLOT2 PMID: 28503944
- Results provide evidence that Flot2 plays an important role in the progression of nasopharyngeal carcinoma cells, which may be partially related to its interaction with PLCD3. PMID: 29115528
- Flot-2 protein expression was significantly elevated in cancerous tissues and Flot-2 played pivotal roles in the development and progression of cancers. Increased expression of Flot-2 was correlated to a poor prognosis in cancer patients. Review. PMID: 27981826
- Data indicate miR-802 as a tumor suppressor in prostate cancer (PCa) progression and elucidated a novel mechanism of the miR-802/Flotillin-2 (Flot2) axis in the regulation of epithelial-mesenchymal transition (EMT), which may be a potential therapeutic target. PMID: 28188157
- We demonstrated that LXR stimulation decreases mRNA and protein expression of FLOT2 and DHHC5 in MCF-7 cells. LXR stimulation also reduces Akt phosphorylation and its localization at the plasma membrane PMID: 28739689
- Ectopic Flot2 could significantly reverse miR-485-mediated inhibition of metastasis and EMT, demonstrating Flot2 downregulation is involved in function of miR-485 PMID: 27262438
- Western blot experiments designed to detect flotillin 2, TMEM256, Rab3B and LAMTOR1 showed that the level of these proteins was higher in urinary exosomes from prostate cancer patients compared to healthy males, and ELISA-based detection of flotillin 2 and PARK7 showed that the combination of these proteins was able to distinguish prostate cancer patients and healthy controls with 68% sensitivity and 93% specificity PMID: 27664330
- This study presents the endocytic pathways of internalization for muscarinic type 3 receptor and flotillin-1/2 in salivary gland epithelial cells. knockdown of flot-1 or -2 by flotillin-specific siRNA prevented internalization and reduced the endocytic efficiency of muscarinic type 3 receptor. PMID: 27221048
- There was a strong association between polymorphisms of flotillin-2 gene and CAD in the Chinese Han population PMID: 26556629
- Flot-2 exerts a pro-neoplastic role in NPC and is involved in tumor progression and metastasis. Moreover, Flot-2 exerts its role through NF-kappaB and PI3K/Akt3 signaling. PMID: 26206082
- Positive expression of Flot-2 protein may be an independent biomarker for poor prognosis in oral squamous cell carcinoma. PMID: 26339392
- Flot2 is an indispensable member for TGF-beta signaling, which is essential for the epithelial-mesenchymal transition process in nasopharyngeal carcinoma metastasis PMID: 25909165
- increased expression of Flot-2 and EGFR in non-small cell lung cancer patients is inversely proportional to the disease prognosis. PMID: 26161893
- that miR-449a suppressed Flot2 expression results in decreased cell invasion through repressing TGF-beta-mediated-epithelial-mesenchymal transition PMID: 26576674
- Knockdown of FLOT2 decreases breast cancer cell proliferation. Silencing of FLOT2 enhanced the transcriptional activity of FOXO factors by decreasing its phosphorylation through inhibiting the PI3K/Akt signaling pathway. PMID: 25738752
- Our findings provided that high FLOT2 expression was associated with poor outcomes in non-small cell lung cancer patients PMID: 25755751
- FLOT2 may serve as an oncogene in the development of cervical cancer PMID: 25755754
- Flotillin 2 (FLOT2) is a direct target of microRNA-34a and the miR-34a/FLOT2 pathway plays a key role in melanoma proliferation and metastasis. PMID: 25403318
- Flotillin-2 is plays a role in the initial steps of skeletal myogenesis. PMID: 25105415
- results suggest that the increased expression of Flot-2 protein is a novel higher sensitivity biomarker that can predict lymph node metastases in NPC. PMID: 25014228
- Our data suggest that FLOT2 is a novel molecule involved in renal cell carcinoma progression PMID: 25053596
- Study suggests the Flot2 protein expression is correlated with cancer progression and poor prognosis in gastric carcinomas, probably due to its role in the regulation of cell proliferation, migration, and invasion in gastric carcinoma cells. PMID: 24854103
- The FLOT2 is abundantly expressed in term villous placental CTs and endothelial cells, and in comparison, expression of these proteins in the ST is reduced. PMID: 23064789
- Depletion of either flotillin-1 or flotillin-2 resulted in downregulation of ErbB3 and a selective reduction of ErbB2-ErbB3 receptor complexes. PMID: 24747692
- Flotillins directly interact with gamma-catenin and regulate epithelial cell-cell adhesion. PMID: 24391950
- High FLOT2 protein expression was associated with poor outcomes in patients with breast cancer. PMID: 23945257
- We have identified flotillin 1 and 2 as new partners of the cadherin complexes PMID: 24046456
- Results identify reggie-1 as a regulator of the Rab11a/SNX4-controlled sorting and recycling pathway. PMID: 23825023
- By virtue of its abundant expression in enterocytes, flotillin-2 must have an essential function in intestinal physiology, especially in the colon. PMID: 23983584
- Flot2 is an important regulator of mammary tumor-derived lung metastasis PMID: 23146906
- a positive correlation exists between flotillin2 and erbB2 expression levels PMID: 23658725
- Report role for flotillin 1/2 in interactions of lung epithelial cells with silica nanoparticles. PMID: 22669515
- we describe how flotillin-1 and -2 contribute to the stabilization of ErbB2 at the cell surface in breast cancer tissue PMID: 22869152
- results support predominant formation of flotillin-1 and -2 hetero-oligomers in resting and chemokine-stimulated human T-cells which may importantly contribute to structuring of the uropod. PMID: 23012365
- by promoting EGFR internalization, reggie-1 restricts EGFR signaling involved in E-cadherin macropinocytosis and recycling and regulate adherens junction formation PMID: 22438585
- potentially relevant protein substrates of DHHC5 PMID: 22081607
- Reggie-1 (flotillin-2) dynamically colocalizes with KIF9 in living cells PMID: 21119006
- flotillins have a role in NPC1L1-mediated cholesterol uptake and NPC1L1-flotillins-postive cholesterol-enriched membrane microdomains are involved in the mechanism for efficient cholesterol absorption PMID: 21187433
- Studies indicate that spatial link between PrP and the microdomain-forming protein flotillins may contribute to PrP signaling, leading to thelocal assembly of membrane protein complexes at sites involved in cellular communication. PMID: 20515742
- In hematopoietic cells, flotillins provide intrinsic cues that govern segregation of certain microdomain-associated molecules during immune cell polarization. PMID: 20027317
- Flot-2 overexpression is associated with melanoma progression, with increased PAR-1 expression, and with transformation of SB2 melanoma cells to a highly metastatic line. PMID: 15492257
- flotillin-2 identified and immunolocalized in the caveola-vesicle complexes (CVC )present in erythrocytes infected with P. vivax PMID: 16521037
- flotillin-2 has a role in lymph node metastasis in melanoma PMID: 17013097
- The results showed that flotillin-1 can interact with arginase1, and hence arginase activity was up-regulated by 26.8%. PMID: 17113085
- These lines of evidence suggested that a Gq-coupled receptor activates specifically p38 MAPK through lipid rafts and Src kinase activation, in which flotillins positively modulate the Gq signaling. PMID: 17307333
- Coassembly of flotillin1 and flotillin2 into microdomains induces membrane curvature, the formation of plasma-membrane invaginations morphologically similar to caveolae, and the accumulation of intracellular vesicles. PMID: 17600709
- Reggie-1/flotillin-2 microdomains form independent of actin PMID: 17854803
- deletion mutants of reggie-1/flotillin-2 accumulate in the Golgi complex in HeLa and Jurkat cells, suggesting Golgi-dependent trafficking of reggie-1/flotillin-2 PMID: 18237819
- Flotillin 2 is a direct transcriptional target of the p53 family member genes in human cancer cells. PMID: 18296650
- The interaction of flotillin-2 with amyloid precursor protein (APP) promotes the clustering of APP at the cell surface. PMID: 18337418
顯示更多
收起更多
-
亞細胞定位:Cell membrane; Peripheral membrane protein. Membrane, caveola; Peripheral membrane protein. Endosome. Membrane; Lipid-anchor. Note=Membrane-associated protein of caveolae.
-
蛋白家族:Band 7/mec-2 family, Flotillin subfamily
-
組織特異性:In skin, expressed in epidermis and epidermal appendages but not in dermis. Expressed in all layers of the epidermis except the basal layer. In hair follicles, expressed in the suprabasal layer but not the basal layer. Also expressed in melanoma and carci
-
數據庫鏈接:
Most popular with customers
-
-
YWHAB Recombinant Monoclonal Antibody
Applications: ELISA, WB, IHC, IF, FC
Species Reactivity: Human, Mouse, Rat
-
Phospho-YAP1 (S127) Recombinant Monoclonal Antibody
Applications: ELISA, WB, IHC
Species Reactivity: Human
-
-
-
-
-
VDAC1 Recombinant Monoclonal Antibody
Applications: ELISA, WB, IHC
Species Reactivity: Human, Mouse, Rat